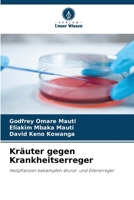
Kräuter gegen Krankheitserreger (German Edition) 6206157717 Book Cover
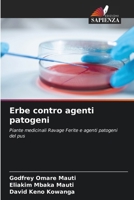
Erbe contro agenti patogeni (Italian Edition) 6206149536 Book Cover
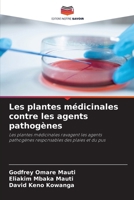
Les plantes médicinales contre les agents pathogènes (French Edition) 6206150348 Book Cover

Godfrey Omare Mauti
Books by Godfrey Omare Mauti

Oceanic Findings Applied In Destruction Of Diseases: Bioactive Secondary Metabolites from Sea Sponge (Clathria indica) vs urinary Tract Pathogens
Out of Stock

Prevention, Fighting & Eradication of Malaria in Africa
Out of Stock

Herbs versus Pathogens
Out of Stock
Kräuter gegen Krankheitserreger (German Edition)
Out of Stock

Ervas versus Patógenos (Portuguese Edition)
Out of Stock
Erbe contro agenti patogeni (Italian Edition)
Out of Stock

Ziola kontra patogeny (Polish Edition)
Out of Stock
Les plantes médicinales contre les agents pathogènes (French Edition)
Out of Stock

Zapobieganie, zwalczanie i eliminacja malarii w Afryce (Polish Edition)
Out of Stock

Prevenção, combate e erradicação da malária em África (Portuguese Edition)
Out of Stock

Prevenzione, lotta ed eradicazione della malaria in Africa (Italian Edition)
Out of Stock

Prävention, Bekämpfung und Ausrottung von Malaria in Afrika (German Edition)
Out of Stock

Prévention, lutte et éradication du paludisme en Afrique (French Edition)
Out of Stock



